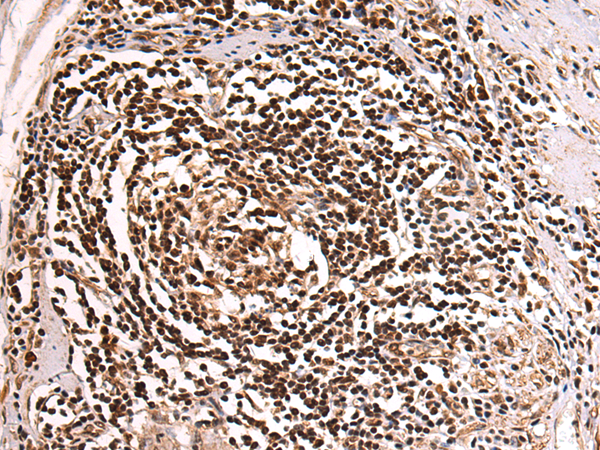
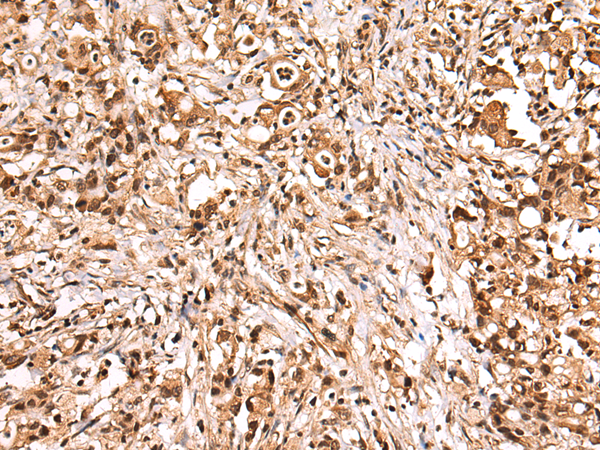
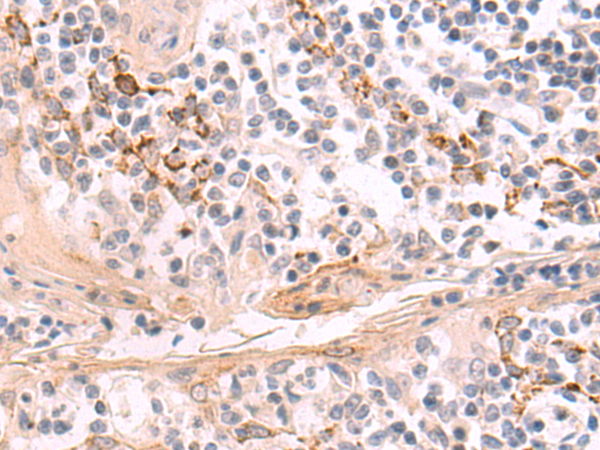

-
分类: 科研抗体货号: P10431别名: RNUXA应用: IHC反应种属: Human, Mouse, Rat
-
分类: 科研抗体货号: P10434别名: Hkp1; mtTFB2应用: IHC反应种属: Human
-
分类: 科研抗体货号: P10449别名: TSD应用: WB,IHC反应种属: Human, Mouse, Rat
-
分类: 科研抗体货号: P10430别名: BTCD; Rts2; KIN17应用: IHC反应种属: Human, Mouse
-
分类: 科研抗体货号: P10448别名:应用: WB,IHC反应种属: Human, Mouse, Rat
-
分类: 科研抗体货号: P10461别名: LAP70; LALP70; LYSAL1; UDPase; NTPDase-4应用: IHC反应种属: Human, Mouse
-
分类: 科研抗体货号: P10447别名: MIR; IDOL应用: WB,IHC反应种属: Human, Mouse, Rat
-
分类: 科研抗体货号: P10460别名: HLP4应用: WB,IHC反应种属: Human, Mouse, Rat
-
分类: 科研抗体货号: P10445别名: PAP; PDCD9; S30mt; MRP-S30应用: IHC反应种属: Human, Mouse
-
分类: 科研抗体货号: P10458别名: GNRPX应用: WB,IHC反应种属: Human, Mouse, Rat

鄂公网安备42018502007531号
鄂公网安备42018502007531号

